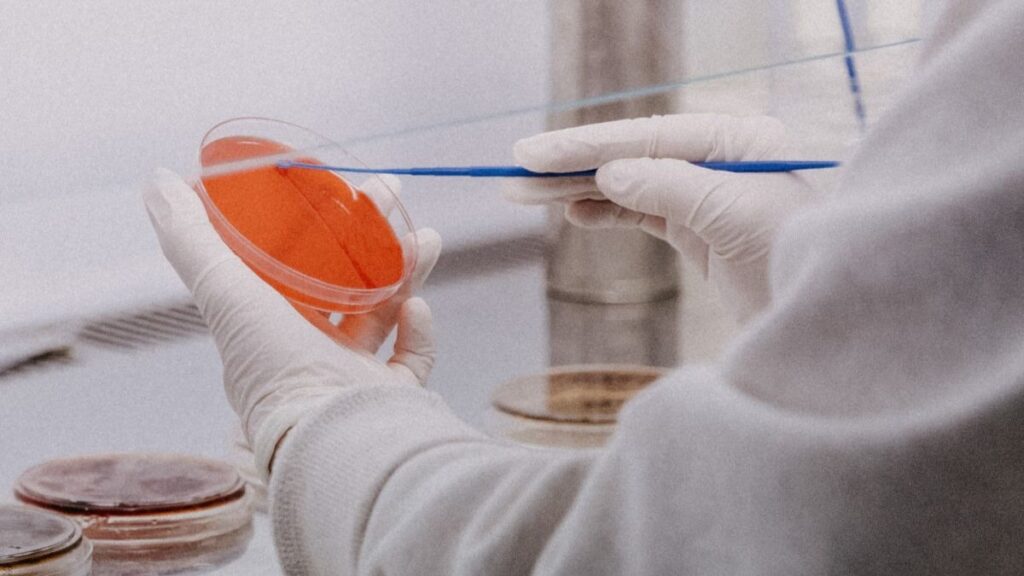

Desde que comenzó la pandemia del coronavirus, 55,6 millones de personas se han contagiado en el mundo, y el número de víctimas mortales asciende a 1,34 millones. Esta semana, el director regional de la Organización Mundial de la Salud para Europa, Hans Kluge, ha explicado que las muertes por Covid-19 han aumentado en un 18% en las dos últimas semanas. En estos momentos el 26% del total de fallecimientos por coronavirus en el mundo se concentran en Europa, y el 28% de los contagios.
Cifras del Covid-19 en Europa
El director ha alertado que en Europa muere una persona de coronavirus cada 17 segundos, lo que se traduce en que 3,5 personas fallecen a causa de la enfermedad en apenas un minuto. Solo la semana pasada se contabilizaron casi 30.000 muertes en el continente. Y añade que más del 80% de los países europeos tienen una incidencia de más de 100 casos por cada 100.000 habitantes en las últimas dos semanas.
Una cifra alarmante, que está provocando que cada vez más sistemas sanitarios estén colapsados. Francia y Suiza son uno de los mejores ejemplos de ello. En Francia las UCI han estado durante más de siete días por encima del 95% de su capacidad, mientras que en Suiza las Unidades de Cuidados Intensivos están al 100%.
Sobre el uso obligatorio de la mascarilla, Hans Kluge asegura que si el 95% de la población utilizara la mascarilla de manera adecuada, se podrían evitar los confinamientos.
Por último, ha explicado que se están registrando daños colaterales terribles por los confinamientos, como el aumento de personas que sufren problemas mentales o que abusan del alcohol.
Países con más fallecidos por coronavirus en el mundo
- Estados Unidos: EE.UU es el país con más víctimas mortales por Covid-19, con 254.413 fallecidos. Con más de 11,9 millones de contagios, muchos culpan a la Administración Trump del descontrol. Donald Trump siempre se ha negado a llevar mascarilla, y durante la campaña electoral no ha dudado en organizar actor multitudinarios.
- Brasil: el segundo puesto en el ranking es para Brasil, con 168.613 víctimas. Es el tercer país a nivel global con más casos, y el segundo con más muertes. Jair Bolsonaro, su presidente, dio positivo en Covid-19.
- India: India aparece en tercer lugar, con 132.726 muertes por coronavirus. El segundo país más poblado del mundo ya supera los nueve millones de contagios.
- México: en México 100.823 personas han muerto por la enfermedad. Con más de un millón de contagios, el sistema de salud está completamente saturado y la economía atraviesa momentos muy críticos.
- Reino Unido: el país europeo con más muertes por Covid-19 es Reino Unido, con 54.286. La segunda ola ha castigado con dureza al país, de forma que el Gobierno ha decretado un nuevo confinamiento hasta el próximo 2 de diciembre.
Estos son los datos que se manejan en la actualidad sobre la crisis del Covid-19.